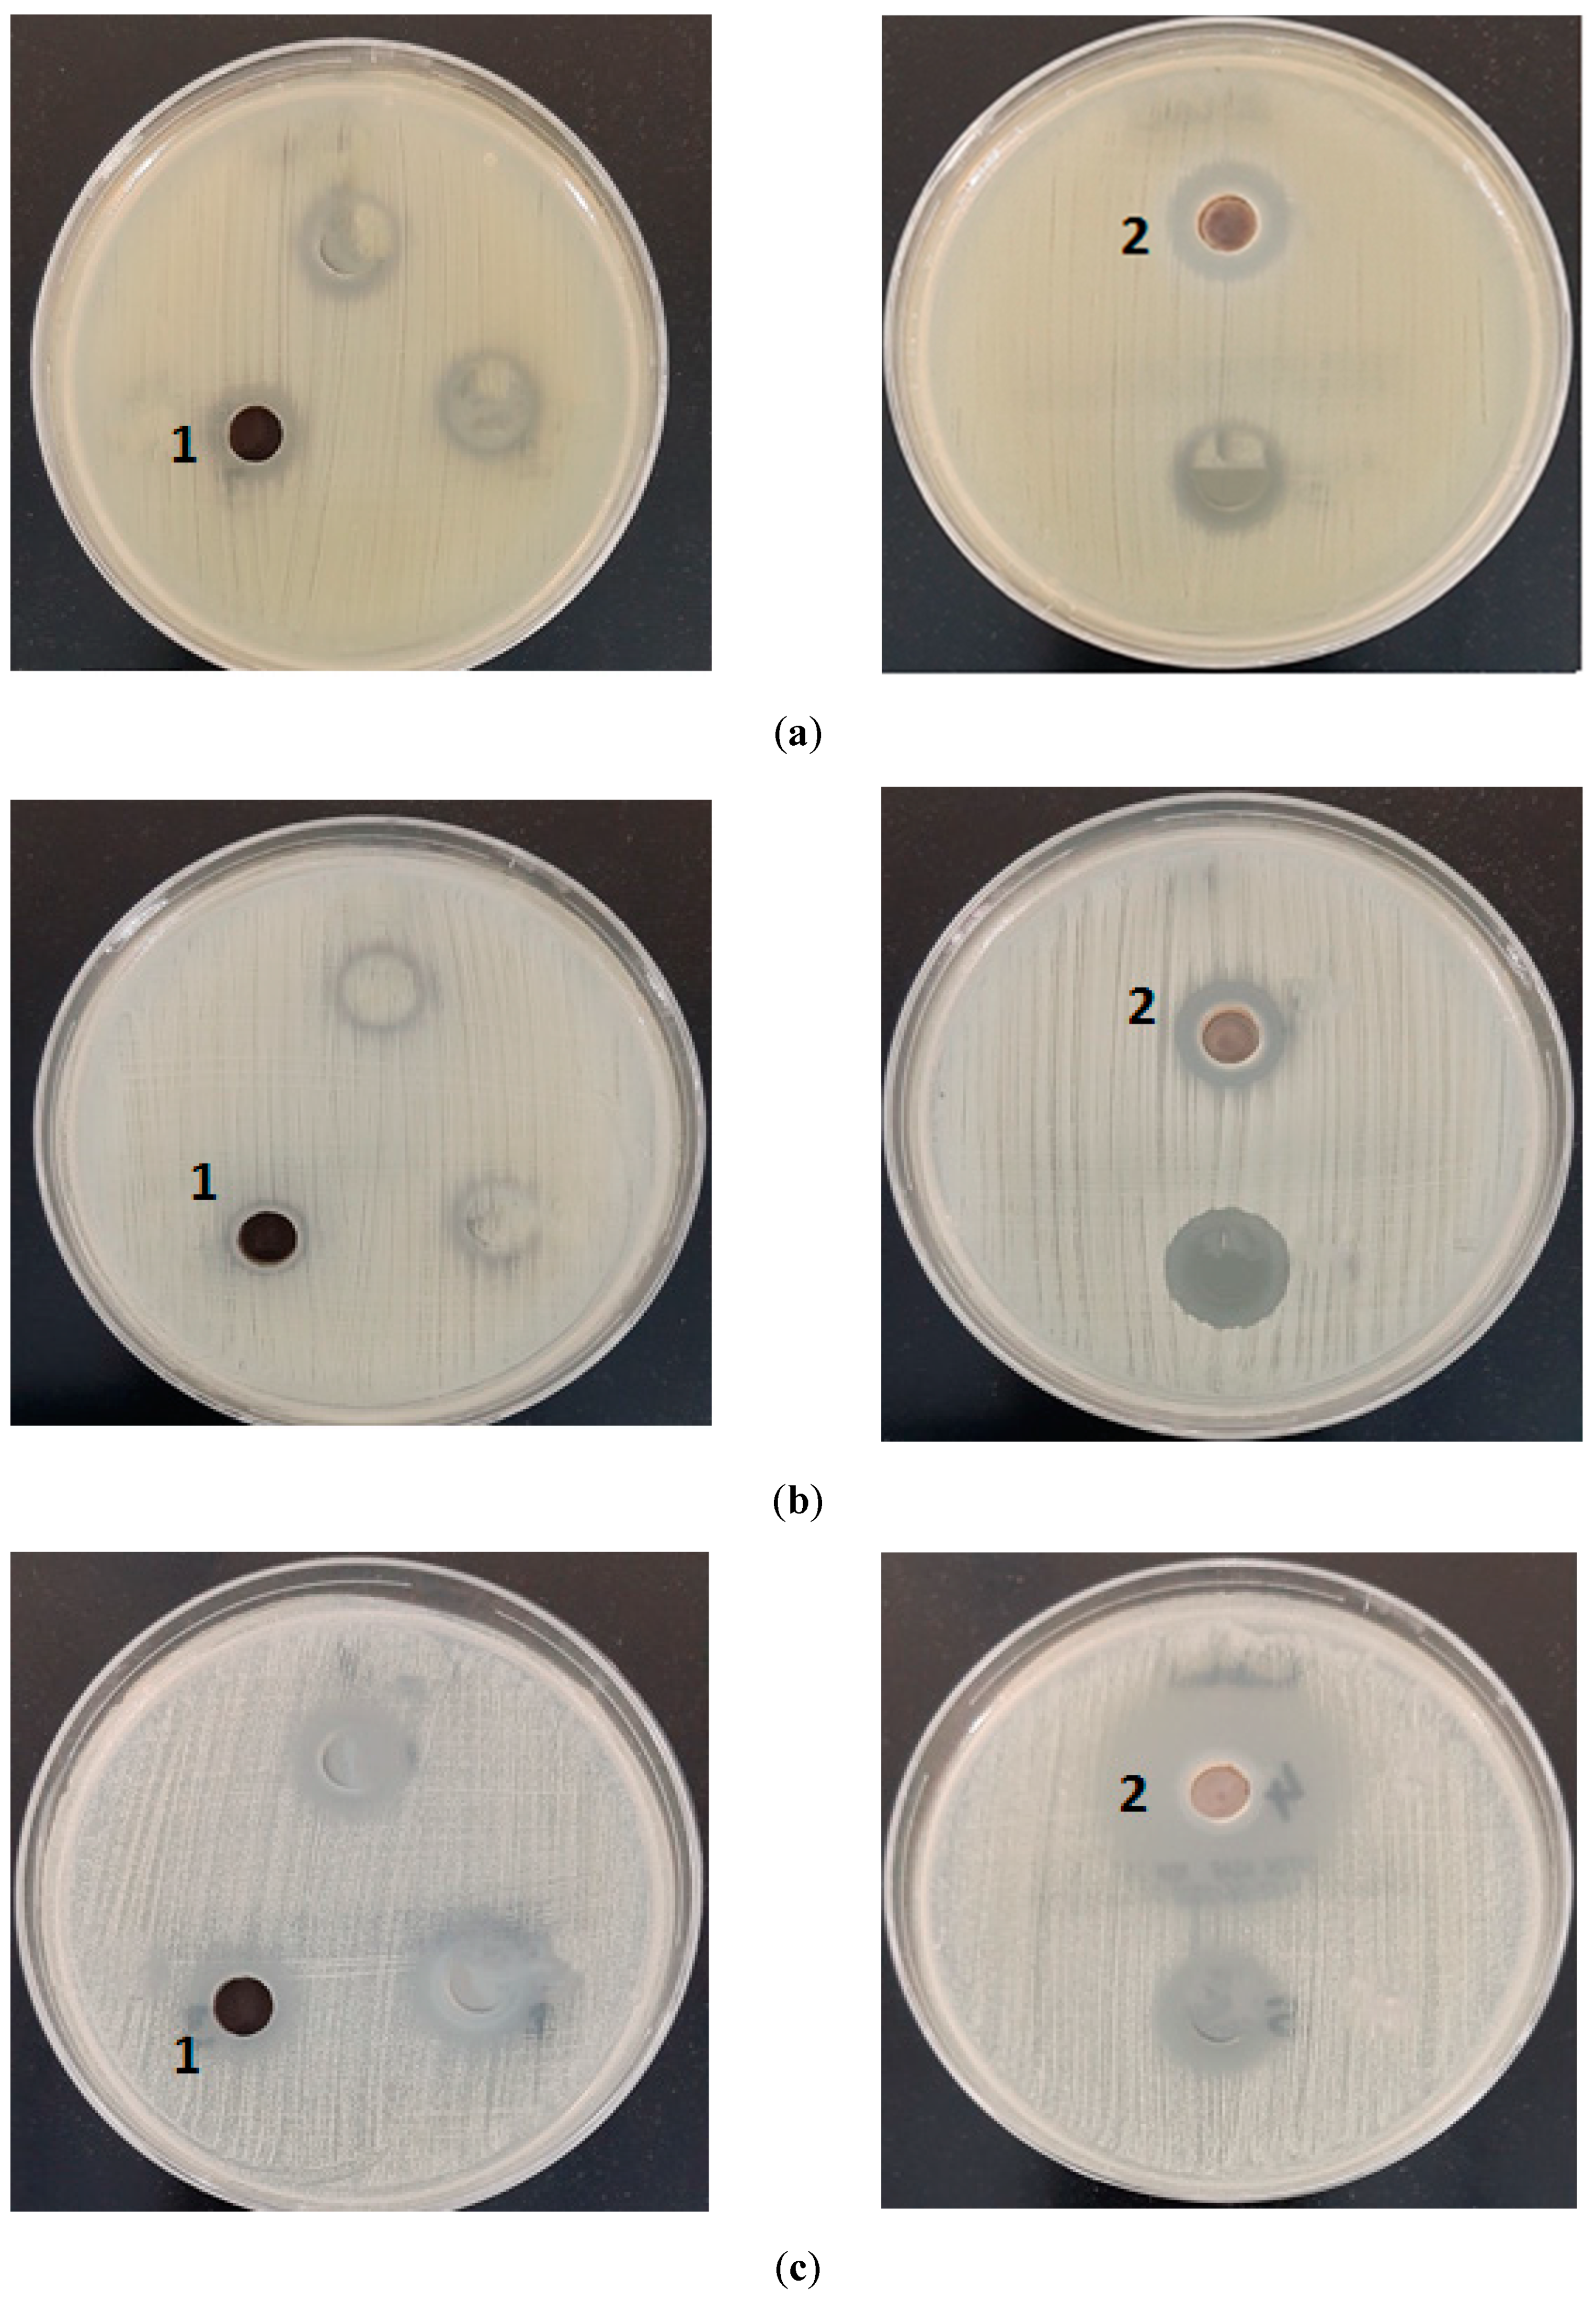

Synthesis, Characterization, and Antimicrobial of MnO and CdO Nanoparticles by Using a Calcination Method
Abstract
:1. Introduction
2. Experimental
2.1. Materials
2.2. Synthesis of the [Mn(PVA)(P-ABA)(H2O)3]·H2O and [Cd(PVA)(P-ABA)(H2O)3] Complexes
2.3. Synthesis of Manganese Oxide and Cadmium Oxide Nanoparticles
2.4. Material Characterization
2.5. Antimicrobial Activity of Manganese Oxide and Cadmium Oxide Nanoparticles
3. Result and Discussion
3.1. Characterization
3.1.1. Elemental Analyses of Complexes
3.1.2. FT-IR Spectroscopy
3.1.3. Optical Characterization and Magnetic Moment
3.1.4. Thermal Analysis
Thermal Analysis of [Mn(PVA)(P–ABA)(H2O)3]·H2O
Thermal Analysis of [Cd(PVA)(P–ABA)(H2O)3]
3.1.5. Kinetic Analysis
3.1.6. Thermodynamic Parameters
Kinetic Compensation Impact
3.1.7. X-ray Powder Diffraction (XRD)
3.1.8. Morphological Studies
4. Biological Activity
5. Conclusions
Author Contributions
Funding
Institutional Review Board Statement
Informed Consent Statement
Data Availability Statement
Acknowledgments
Conflicts of Interest
References
- López–Serrano, A.; Muñoz–Olivas, R.; Sanz–Landaluze, J.; Olasagasti, M.; Rainieri, S.; Cámara, C. Comparison of bioconcen-tration of ionic silver and silver nanoparticles in zebrafish eleutheroembryos. Environ. Pollut. 2014, 191, 207–214. [Google Scholar] [CrossRef] [PubMed]
- Burda, C.; Chen, X.; Narayanan, R.; El-Sayed, M.A. Chemistry and properties of nanocrystals of different shapes. Chem. Rev. 2005, 105, 1025–1102. [Google Scholar] [CrossRef] [PubMed]
- Athar, T.; Topnani, N.; Hakeem, A.; Ahmed, W. Synthesis and characterization of MnO2 and CdO nanoparticles. Adv. Sci. Lett. 2012, 5, 39–42. [Google Scholar] [CrossRef]
- Marouzi, S.; Sabouri, Z.; Darroudi, M. Greener Synthesis and medical applications of metal oxide nanoparticles. J. ceramint. 2021, 47, 19632–19650. [Google Scholar] [CrossRef]
- Xiao, W.; Wang, D.; Lou, X.W. Shape–controlled synthesis of MnO2 nanostructures with enhanced electrocatalytic activity for oxygen reduction. J. Phys. Chem. 2010, 114, 1694–1700. [Google Scholar] [CrossRef]
- Xu, G.; Xu, Y.; Sun, H.; Fu, F.; Zheng, X.; Taoli, J.; Yang, S.; Sun, S. Facile synthesis of porous MnO/C nanotubes as a high capacity anode material for lithium ion batteries. Chem. Comm. 2012, 48, 8502–8504. [Google Scholar] [CrossRef]
- Yan, D.; Yan, P.; Yue, G.; Chang, J.; Yang, Q.; Qu, D.; Geng, Z.; Chen, J.; Zang, G.; Zhuo, R. Self-assembled flower- like hier-archical spheres and nanobelts of manganese oxide by hydrothermal method and morphology control of them. Chem.Phys. Lett. 2007, 440, 134–138. [Google Scholar] [CrossRef]
- Wang, X.; Li, Y. Synthesis formation mechanism of manganese dioxide nanowires/nanorods. Chem. 2003, 9, 300–306. [Google Scholar] [CrossRef]
- Ching, S.; Welch, E.; Hughes, S.; Bahadoor, A.; Suib, S. Nonaqueous sol-gel syntheses of microporous manganese oxides. Chem. Mater. 2002, 14, 1292–1299. [Google Scholar] [CrossRef]
- D’Souza, L.; Richards, R. Synthesis of metal-oxide nanoparticles: Liquid–solid transformations. In Synthesis, Properties, and Applications of Oxide Nanomaterials; Rodriguez, J.A., Fernández-García, M., Eds.; International University Bremen: Bremen, Germany, 2007; pp. 81–117. [Google Scholar]
- Suslick, K.S.; Choe, S.B.; Cichowlas, A.A.; Grinstaff, M.W. Sonochemical synthesis of amorphous iron. Nature 1991, 353, 414–416. [Google Scholar] [CrossRef]
- Askarinejad, A.; Morsali, A. Syntheses and Charactrization of CdCO3 and CdO Nanoparticles by Using Sonochemical Method. Mater. Lett. 2008, 62, 478–482. [Google Scholar] [CrossRef]
- Gulino, A.; Castelli, F.; Dapporto, P.; Rossi, P.; Fragalà, I. Synthesis and Characterization of Thin Films of Cadmium Oxide. Chem. Mater. 2002, 14, 704–709. [Google Scholar] [CrossRef]
- Mohamed, M.; Halawy, S. Non-isothermal decomposition of cadmium itaconate monohydrate in different atmospheres. J. Anal. Appl. Pyrolysis 2002, 65, 287–300. [Google Scholar] [CrossRef]
- Ni, X.; Li, M.J.; Jiao, D.; Huang, J.; Zhang, X. Microwave characteristics of Co/TiO2 nanocomposites prepared by mechanochemical synthesis. J. Alloys Compd. 2009, 468, 386–391. [Google Scholar] [CrossRef]
- Xu, X.; Tang, J.; Nishimura, T.; Hao, L. Synthesis of Ca–a–SiAlON phosphors by a mechanochemical activation route. Acta Mater. 2011, 59, 1570–1576. [Google Scholar] [CrossRef]
- Anner, G.E. Physical Vapor Deposition; Sputtering. In Planar Processing Primer; Springer: Dordrecht, The Netherlands, 1990. [Google Scholar] [CrossRef]
- Swain, A.K. Review on green synthesis of silver nanoparticles by physical, chemical and biological methods. Int. J. Sci. Eng. Res 2016, 7, 551–554. [Google Scholar] [CrossRef]
- Uskoković, V.; Drofenik, M. Synthesis of materials within reverse micelles. Surf. Rev. Lett. 2005, 12, 239–277. [Google Scholar] [CrossRef]
- Kumar, D.S.; Kumar, B.J.; Mahesh, H.M. Quantum nanostructures (QDs): An overview. Syn. Inorg. Nanomater. 2018, 59–88.–88. [Google Scholar] [CrossRef]
- Thiagarajan, S.; Tsai, T.H.; Chen, S.M. 099. Electrochemical Fabrication of Nano Manganese Oxide Modified Electrode for Detection of H2O2. Int. J. Electrochem. Sci. 2011, 6, 2235–2245. [Google Scholar]
- Li, J.; Wang, Y.J.; Zou, B.S.; Wu, X.C.; Lin, J.G.; Guo, L.; Li, Q.S. Magnetic properties of nanostructured Mn oxide particles. Appl. Phys. Lett. 1997, 70, 3047–3049. [Google Scholar] [CrossRef]
- Shchukin, D.G.; Sviridov, D.V.; Kulak, A.I. Integrating photoelectrochemical semiconductor sensor for sulphide ion deter-mination. Sens. Actuators B Chem. 2001, 76, 556–559. [Google Scholar] [CrossRef]
- Dong, W.; Zhu, C. Optical properties of surface-modified CdO nanoparticles. Opt. Mater. 2003, 22, 227–233. [Google Scholar] [CrossRef]
- Pandey, B.K.; Shahi, A.K.; Gopal, R. Optical and electrical transport properties of MnO nanoparticles. Mater. Focus. 2013, 2, 221–226. [Google Scholar] [CrossRef]
- Ould-Ely, T.; Prieto-Centurion, D.; Kumar, A.; Guo, W.; Knowles, W.V.; Asokan, S.; Wong, M.S.; Rusakova, I.; Luüttge, A.; Whitmire, K.H. Manganese (II) oxide nanohexapods: Insight into controlling the form of nanocrystals. Chem. Mater. 2006, 18, 1821–1829. [Google Scholar] [CrossRef]
- Thackeray, M.; Kock, A.; de Piocciotto, L.; Pistoia, G. Synthesis and Characterization of γ-MnO2 from LiMn2O4. J. Power Sources 1989, 26, 355–363. [Google Scholar] [CrossRef]
- Kaushik, A.; Jayant, R.; Sagar, V.; Nair, M. The Potential of Magneto-Electronic Nanocarriers Drug Delivery. Expert Opin. Drug Deliv. 2014, 11, 1635–1646. [Google Scholar] [CrossRef]
- Chen, T.; Valentin, O. Controllable Catalysis with Nanoparticles: Bimetallic Alloy Systems and Surface Adsorbates. ACS Catal. 2016, 6, 4025–4033. [Google Scholar] [CrossRef] [Green Version]
- Lee, W.J.; Jeong, S.; Lee, H.; Kim, B.J.; An, K.H.; Park, Y.K.; Jung, S.C. Facile synthesis of iron-ruthenium bimetallic oxide nanoparticles on carbon nanotube composites by liquid phase plasma method for supercapacitor. Korean J Chem Eng. 2017, 34, 2993–2998. [Google Scholar] [CrossRef]
- Saxena, S.; Saxena, U. Development of Bimetal Oxide Doped Multifunctifunctional Polymer nanocomposite for water treat-ment. Int. Nano Lett. 2016, 6, 223–234. [Google Scholar] [CrossRef] [Green Version]
- Kumar, R.; Gokulakrishnan, N.; Kumar, R.; Krishna, V.M.; Saravanan, A.; Supriya, S.; Somanathan, T. Can Be a Bimetal Oxide ZnO-MgO Nanoparticles Anticancer Drug Carrier and Deliver Doxorubicin Adsorption/Release Study. J. Nanosci. Nanotechnol. 2015, 15, 1543–1553. [Google Scholar] [CrossRef]
- Shaukat, A.; Anwar, H.; Mahmood, A.; Hussain, G.; Rasul, A.; Ijaz, M.; Faisal, M.; Ibrahim, M.; Ali, A. Synthesis cum char-acterization of MgO and MnO nanoparticles and their assessment as antidiabetic and antioxidative agents in diabetic rat model. Physica B Condens. Matter 2021, 602, 412–570. [Google Scholar] [CrossRef]
- Somasundaram, G.; Rajan, J.; Sangaiya, P. Dilip, Hydrothermal synthesis of CdO nanoparticles for photocatalytic and anti-microbial activities. Results Materials 2019, 4, 100044. [Google Scholar] [CrossRef]
- Su, L.M.; Grote, N.; Schmitt, F. Diffuse Planar InP Biopolar Junction Transistor with a Cadmium Oxide Film Emitter. Electron. Lett. 1985, 20, 716–717. [Google Scholar] [CrossRef]
- Su, L.M.; Grote, N.; Schmitt, F. Diffused planar InP bipolar transistor with a cadmium oxide film emitter. Electron. Lett. 1984, 20, 716–717. [Google Scholar] [CrossRef]
- Ocampo, I.; Ferandez, A.; Sabastian, P. Low Resistivity Transparent Conducting Thin Film Deposited by DC Reactive Magnetron Sputtering at Room Temperature. Semicond. Sci. Technol. 1993, 8, 750. [Google Scholar] [CrossRef]
- Benko, F.; Koffyberg, F. Quantum efficiency and Optical Transition of CdO Photoanodes. Solid State Commun. 1986, 57, 901–990. [Google Scholar] [CrossRef]
- Gurumugan, K.; Mangalarag, D.; Narayandass, A.; Sekar, K.; Vallabham, C. Characterization of Transparent conducting cdO films Deposited by Spray Pyrolysis. Semicond. Sci. Technol. 1994, 9, 1827. [Google Scholar] [CrossRef]
- Xiangfeng, C.; Xingqin, L.; Guangyao, M. Effects of CdO dopant on The Gas Sensitivity Properties of ZnFe2O4 Semi-conductors. Sens. Actuators B Chem. 1995, 65, 64–67. [Google Scholar] [CrossRef]
- Rane, Y.; Raghuwanshi, M.; Koli, R.; Gosavi, S.; Deshpande, N. Visible-light assisted CdO nanowires photocatalyst for toxic dye degradation studies. Optic. 2019, 133, 535–544. [Google Scholar] [CrossRef]
- Sivakumar, S.; Venkatesan, A.; Soundhirarajan, P.; Khatiwada, C. Synthesis, characterizations and anti-bacterial activities of pure and Ag Doped CdO Nanoparticles by Chemical Method. Spectrochim. Acta A Mol. Biomol. Spectrosc. 2014, 136, 1751–1759. [Google Scholar] [CrossRef]
- Hendrawan, H.; Khoerunnisa, F.; Sonjaya, Y.; Putri, A. Poly (vinyl alcohol)/glutaraldehyde/Premna oblongifolia merr extract hydrogel for controlled-release and water absorption application. IOP Conf. Ser.: Mater. Sci. Eng. 2019, 509, 012048. [Google Scholar] [CrossRef]
- Nagarkar, R.; Patel, J. Polyvinyl Alcohol: A Comprehensive Study. ASPS 2019, 4, 34–44. [Google Scholar]
- Hernandez, G.; Ricardo, M.; Morales, P.; Sanchez, M. Polyvinyl alcohol based-drug delivery system for cancer treatment. Int. J. Pharm. 2021, 600, 120478. [Google Scholar] [CrossRef] [PubMed]
- Al-Fakeh, M.; Alsaedi, R. Synthesis, Characterization, and Antimicrobial Activity of CoO Nanoparticles from a Co(II) Complex Derived from Polyvinyl Alcohol and Aminobenzoic Acid Derivative. Sci. World J. 2021, 2021, 1–11. [Google Scholar] [CrossRef] [PubMed]
- Un Nisa, Z.; Tashfeen, A. Para-Aminobenzoic Acid-A Substrate of Immense Significance. Mini-Rev. Org. Chem. 2020, 6, 686–700. [Google Scholar] [CrossRef]
- Roik, N.; Belyakova, L. IR Spectroscopy, X-ray Diffraction and Thermal Analysis Studies of Solid “β-Cyclodextrin—Pa-ra-Aminobenzoic Acid” Inclusion Complex. Phys. Chem. Solid State. 2011, 12, 168–173. [Google Scholar]
- Aly, A.A.; Ghandour, M.; Alfakeh, M.S. Synthesis and characterization of transition metal coordination polymers derived from 1, 4-benzenedicarboxylate and certain azoles. Turk. J. Chem. 2012, 36, 69–79. [Google Scholar]
- Siddaiah, T.; Ojha, P.; Kumar, G.; Ramu, C. Structural, Optical and Thermal Characterizations of PVA/MAA: EA Polyblend Films. Mater. Res. 2018, 21, e20170987. [Google Scholar] [CrossRef] [Green Version]
- Gainar, A.; Stevens, J.; Suljoti, E.; Xiao, J.; Gonlak, R.; Aziz, E.; Schrorder, S. The Structure of p-Aminobenzoic Acid in Water: Studies Combining UV-Vis, NEXAFS and RIXS Spectroscopies. J. Phys. Conf. Ser. 2016, 712, 012034. [Google Scholar] [CrossRef] [Green Version]
- Al-Fakeh, M.; Allazzam, G.; Yarkandi, N. Ni(II), Cu(II), Mn(II), and Fe(II) Metal Complexes Containing 1,3-Bis(diphenylphosphino)propane and Pyridine Derivative: Synthesis, Characterization, and Antimicrobial Activity. Int. J. Biomater. 2021, 2021, 1–12. [Google Scholar] [CrossRef]
- OBA, A.; Osowole, A.A.; Malumi, E.O.; Wakil, S.M. Synthesis and characterization of transition metal coordination polymers derived from 1, 4-benzenedicarboxylate and certain azoles. Rev. J. Chem. 2015, 36, 69–79. [Google Scholar]
- Coats, A.; Redfern, J. Kinetic Parameters from Thermogravimetric Data. Nature 1964, 201, 68–69. [Google Scholar] [CrossRef]

| Compounds | M.F (M.Wt) | Color | Found (Calcd. %) | m.p. °C (Decom.) | Λm Scm2 mol−1 | ||
|---|---|---|---|---|---|---|---|
| C | H | N | |||||
| [Mn(PVA)(P-ABA)(H2O)3]·H2O 1 | C10H19N2MnO8 (350.13) | Light brown | 35.84 (34.30) | 6.05 (5.46) | 8.09 (7.99) | 239–241 | 58 |
| [Cd(PVA)(P-ABA)(H2O)3] 2 | C10H17N2CdO7 (389.58) | White | 31.07 (30.83) | 4.78 (4.39) | 7.63 (7.18) | 290–292 | 36 |
| Assignment | PVA | P-ABA | Mn(II) Complex | Cd(II) Complex |
|---|---|---|---|---|
| VO-H | 3400 | - | 3250 | 3280 |
| VO-H water | - | - | 3337 | 3339 |
| VN-H2 | - | 3234 | 3243 | 3220 |
| VC=N | - | 1640 | 1620 | 1650 |
| VC-OC | 1150 | - | 1178 | 1180 |
| M-O | - | - | 522 | 515 |
| M-N | - | - | 430 | 422 |
| Compound | Wave Number cm−1 | Type of Transition |
|---|---|---|
| Mn(II) complex | 19,685 | d-d transition |
| 35,971 | n→π* | |
| 41,841 | π→π* | |
| Cd(II) complex | 36,363 | n→π* |
| 42,918 | π→π* |
| Complexes | Step | Coats–Redfern | |||
|---|---|---|---|---|---|
| n | r | E | Z × 102 | ||
| [Mn(PVA)(P-ABA)(H2O)3]·H2O | 2nd | 0.00 | 0.9930 | 55.34 | 3.73 |
| 0.33 | 0.9988 | 64.36 | 4.34 | ||
| 0.50 | 0.9993 | 69.52 | 4.69 | ||
| 0.66 | 0.9995 | 73.60 | 4.97 | ||
| 1.00 | 0.9999 | 85.03 | 5.76 | ||
| 2.00 | 1.000 | 124.02 | 8.49 | ||
| [Cd(PVA)(P-ABA)(H2O)3] | 2nd | 0.00 | 0.9808 | 21.90 | 1.47 |
| 0.33 | 0.9857 | 26.41 | 1.78 | ||
| 0.50 | 0.9881 | 29.11 | 1.96 | ||
| 0.66 | 0.9908 | 31.74 | 2.14 | ||
| 1.00 | 0.9935 | 38.18 | 2.50 | ||
| 2.00 | 0.9976 | 62.45 | 4.25 | ||
| Compound | Step | ∆S* | ∆H* | ∆G* |
|---|---|---|---|---|
| Mn(II) complex | 2nd | −249.60 | 58.7 | 184.22 |
| −250.31 | 62.25 | 188.13 | ||
| −250.49 | 71.67 | 197.64 | ||
| −250.56 | 76.91 | 202.95 | ||
| −250.62 | 82.14 | 208.24 | ||
| −250.75 | 138.24 | 264.25 | ||
| Cd(II) complex | 2nd | −248.28 | 42.91 | 160.65 |
| −248.48 | 129.61 | 246.80 | ||
| −248.91 | 161.36 | 278.26 | ||
| −249.71 | 165.17 | 281.69 | ||
| −250.33 | 182.58 | 298.90 | ||
| −251.50 | 192.01 | 308.24 | ||
| ∆H*, ∆G* in Kj mol−1 and ∆S* in Kj mol−1 K−1 | ||||
| Parameters | Manganese Oxide (NPS) | Cadmium Oxide (NPS) |
|---|---|---|
| Empirical formula | MnO | CdO |
| Formula weight | 70.92 | 128.40 |
| Crystal system | Orthorhombic | Cubic |
| a (Å) | 5.630 | 4.694 |
| b (Å) | 5.644 | 4.694 |
| c (Å) | 7.972 | 4.694 |
| α (°) | 90.00 | 90.00 |
| β (°) | 90.00 | 90.00 |
| γ (°) | 90.00 | 90.00 |
| Volume of unit cell (Å3) | 253.35 | 103.46 |
| Particle size (nm) | 42 | 58 |
| Tested Organisms | 1 MnO | 2 CdO |
| Zone of Inhibition in mm | ||
| Staphylococcus aureus | 12 | 16 |
| Staphylococcus epidermidis | - | 20 |
| Enterococcus faecalis | - | 14 |
| Escherichia coli | 12 | 16 |
| Pseudomonas aeruginosa | 11 | 14 |
| Candida albicans | 15 | 30 |
| Aspergillus fumigatus | 12 | 23 |
| Aspergillus flavus | 12 | 15 |
Publisher’s Note: MDPI stays neutral with regard to jurisdictional claims in published maps and institutional affiliations. |
© 2022 by the authors. Licensee MDPI, Basel, Switzerland. This article is an open access article distributed under the terms and conditions of the Creative Commons Attribution (CC BY) license (https://creativecommons.org/licenses/by/4.0/).
Share and Cite
Al-Fakeh, M.S.; Alsaedi, R.O.; Amiri, N.; Allazzam, G.A. Synthesis, Characterization, and Antimicrobial of MnO and CdO Nanoparticles by Using a Calcination Method. Coatings 2022, 12, 215. https://doi.org/10.3390/coatings12020215
Al-Fakeh MS, Alsaedi RO, Amiri N, Allazzam GA. Synthesis, Characterization, and Antimicrobial of MnO and CdO Nanoparticles by Using a Calcination Method. Coatings. 2022; 12(2):215. https://doi.org/10.3390/coatings12020215
Chicago/Turabian StyleAl-Fakeh, Maged S., Roaa O. Alsaedi, Nesrine Amiri, and Gadah A. Allazzam. 2022. "Synthesis, Characterization, and Antimicrobial of MnO and CdO Nanoparticles by Using a Calcination Method" Coatings 12, no. 2: 215. https://doi.org/10.3390/coatings12020215
APA StyleAl-Fakeh, M. S., Alsaedi, R. O., Amiri, N., & Allazzam, G. A. (2022). Synthesis, Characterization, and Antimicrobial of MnO and CdO Nanoparticles by Using a Calcination Method. Coatings, 12(2), 215. https://doi.org/10.3390/coatings12020215






